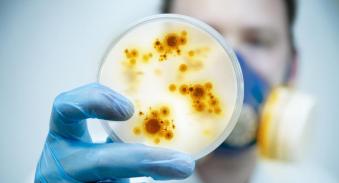
中心静脉导管相关并发症最严重,中心静脉常见并发症的预防及处理

原创 官水木 梅斯肿瘤新前沿 2022-11-07 20:00 发表于上海

中心静脉导管是临床上应用非常广泛的技术,它可以迅速为患者建立静脉通道,进行快速补液、测定中心静脉压力、输注化疗药物等对血管刺激大的药物。在肿瘤患者的常规治疗及抢救中发挥着重要作用。
但中心静脉导管护理不佳或操作不当时,也可能发生一些并发症,如堵管、血栓、感染等。正确识别处理相关并发症可以将患者的损伤降至最低。
1.导管内血栓形成
为了预防导管内血栓形成,可采用脉冲方式冲管,正压封管。用生理盐水冲管,边冲边停顿,使液体在管腔内形成漩涡,防止药物微粒沉积在管腔。
缓慢推注封管液,在推注最后边推封管液边用卡瓣夹住导管,注射器拔出后马上使用正压接头封住导管开口,使管腔内始终保留封管液,尽量避免血液回流到管腔内。

www.veer.com
2.导管打折或贴壁
导管打折或贴壁时,会出现输液不畅或是中心静脉测压不准。为预防导管打折,导管固定应顺穿刺方向。
中心静脉导管贴壁时,可改变患者体位,让患者咳嗽。如果加压推液没有阻力或阻力较小,可以推注无菌盐水以便管尖离开静脉壁。也可以沿导管置人导丝然后拔出原导管,调整导丝位置,再沿导丝置人新导管。
3.穿刺部位出血
常见原因是穿刺过程不顺利,反复穿刺造成静脉损伤。穿刺时应避免反复穿刺损伤血管。扩皮时根据患者身材来估计扩皮深度。如果穿到动脉要立刻拔出穿刺针,用力压迫穿刺部位。
如果已经出现血肿则需要用力压迫穿刺部位稍内侧,必要时可以局部外用止血酶、静脉用止血药物。
要密切观察血肿是否增大,患者有无胸闷、心慌、呼吸困难等症状,注意复查胸片。如果有进行性出血、漏气,需胸腔闭式引流或手术止血。

www.veer.com
4.静脉狭窄
导致静脉狭窄的原因主要包括:反复穿刺插管,血管外组织瘫痕形成导致血管牵拉变形;血管外血肿形成和机化导致血管狭窄;血管内反复穿刺,血管内皮受损导致血管内血栓形成等。
目前,临床上对静脉狭窄还没有比较有效的治疗方法,主要是尽量避免多次穿刺来预防,如果需要反复多次化疗,可以考虑采用PICC等方法替代。
5.心律失常
导管前端达心房或心房入口时,快速输液及冷刺激可诱发心律失常。导管末端进入心房后应根据进入深度将导管拔出适当长度。导管所致感染引起高热也可导致心动过速等心律失常,此时应该及时拔除导管。
6.导管相关性感染
导管相关性感染的发生率约为5%~26%,死亡率约为15%~38%。急诊置管感染机率最高,锁骨下置管感染机率最低,股静脉置管感染机率最高,置管时间越长感染机率越高。
静脉炎、导管细菌定植、导管相关血流感染是导管相关性感染的3种主要形式。静脉炎会在导管出口部位出现硬结或红斑、发热、疼痛;导管细菌定植在导管内会出现细菌的培养阳性;导管相关血流感染则血培养有菌血症。
出现导管相关性感染时,一般先拔出导管并将导管前端剪下做细菌培养,先使用广谱抗生素静脉滴注,待培养结果出来后根据药敏结果调整抗生素。
www.veer.com
7.脱管
脱管多因贴膜粘度降低、无意拽拉、体位改变等原因导致。置管时采用固定夹、缝线、贴膜三重固定可起到较理想的固定作用。对置管病人的操作应动作轻柔,尽量减少颈部或腹股沟等置管部位活动。一旦发生脱管,应立即拔管压迫止血。
参考文献
1.张玉洁, 等. 儿童血液病房中心静脉导管感染危险因素及临床特点分析. 中国实用医药. 2022,17(10): 87-89.
2.尹萌萌, 等. 儿童中心静脉导管相关的血栓形成性及感染性并发症的预防和治疗. 中国生育健康杂志. 2022,33(01): 94-97.
- END -